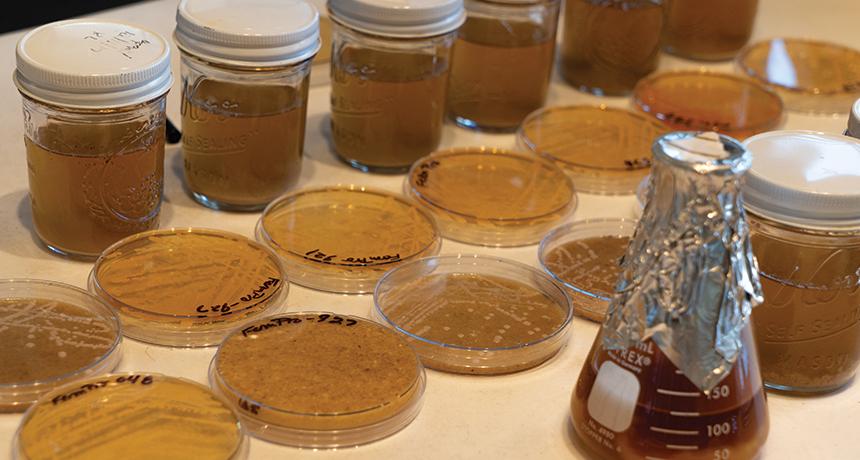

The Art of Non-Alcoholic Spirits
blog
For decades, spirits and cocktails have fostered a culture of craft, connection, and celebration. But over time, cocktail culture has evolved far beyond the buzz!

Written by Luis Ayala, Founder of Rum Central, Got Rum? magazine & The Rum University
People who appreciate aged distillates- regardless of the spirits category- rarely stop to think about the evolutionary paths taken by nature in order to make their beverages possible. We rely on yeast's prowess in "chemical warfare" to produce ethanol, which we later infuse with tannins that were originally evolved by plants as a defense against predation. So while yeast has evolved the ability to produce alcohol to fend off bacteria and fungi, it is humans' appreciation for ethanol that has ultimately ensured the large-scale propagation and perpetuity of yeast- it begs the question: "who serves who?"
It is widely accepted that life originated in water in the form of simple microorganisms similar to modern-day algae. As the geography of the planet changed and land surfaces became exposed, these early lifeforms were able to experiment with mutations and survival strategies aimed at exploiting the living conditions on dry land. Plants became homoichydric; that is, they evolved vascular systems designed to transfer water from the root zone to the opposite extremes above ground.
One of the earliest evolutionary adaptations was photosynthesis- the ability to use the sun's light energy to produce food from carbon dioxide and water molecules. Photosynthesis allows plants to absorb C02 from the atmosphere, but at a price: the same tissues that allow C02 to enter the plants also allow stored water to evaporate.
To mitigate water loss, plants evolved specialized cells that increased the impermeability of their outer membranes, though this ability to synthesize food was not a survival guarantee. Plants also had to evolve ways to store the newly created food in order to cope with changing environmental conditions.
Food storage resulted in increased growth opportunities. As plants got bigger, so did the competition for sunlight. Taller plants could gather more sunlight (for photosynthesis) while the wind carried their seeds farther away.
Of course, growing required specialized structures. Xylem cells were resistant to collapse, supporting the additional weight while functioning efficiently as a vascular system for nutrient transportation. Lignified walls then led to arborescence- plants growing into tree-like shapes. This involved secondary growth, or vascular cambium.
The first plants to develop secondary growth and a woody habit are thought to have been ferns. In as early as the Middle Devonian period, the Wattleza species had already reached heights of 26 feet (eight meters) and a tree-like habit.

Early trees were free-sporing specimens that later evolved into today's main tree groups, known as gymnosperms or seed-producing trees. This group includes all coniferous and nut/fruit-producing trees, including our beloved white oak which is used in the manufacturing of most of today's barrels.
The evolutionary origin of white oaks was shrouded in mystery until a few years ago. There are approximately 125 species in the Americas and around 25 more in Eurasia, but little was known about their origin. According to research conducted by Andrew Hipp of The Morton Arboretum and Paul Manos & John McVay of Duke University, Eurasian white oaks arose from a North American ancestor that migrated to Europe, perhaps by way of the North Atlantic land bridge. The researchers used genomic data, fossil records, and leading-edge analytical methods to answer the question regarding the white oak's mysterious origin.
Plant life has evolved from simple single-cell organisms to complex flowering/seeding structures, some towering 100+ feet (30+ meters) from the ground. As they adapted to their environment, plants evolved offensive and defensive survival strategies- but plant predators also evolved their share of strategies, too. Today we are able to see specimens showcasing winning combinations of such stratagems, living testaments to nature's adaptability and efficiency.
According to Encyclopedia Britannica, "genomic surveys show that plant genomes lack gene sequences that are crucial in animal development; animal genomes lack gene sequences that are crucial in plant development; and fungal genomes have none of the sequences that are important in controlling multi-cellular development in animals or plants."
Such fundamental genetic differences imply that animals, plants, and fungi are indeed very different organisms today, but molecular analyses indicate that they diverged from a single ancestor almost one billion years ago.
As plants evolved into more and more complex forms, so did the organisms that relied on those same plants as their source of food or as their hosts for reproduction.
Fossil evidence indicates that the first lifeforms were bacteria, more than likely extremophiles named for their ability to tolerate the extremes of temperature, salt concentration, radiation, pH, and other environmental factors. Such organisms are part of the division of life known as the Archae, specifically the archaebacteria.
Another bacterial lifeform definitively known to have been among the first to appear on earth is the cyanobacteria. Fossils of cyanobacteria have been uncovered that date back almost 4 billion years. These bacteria are suited to the low oxygen levels that we're present in the planet's atmosphere at that time. The cyanobacteria produced oxygen as waste gas of their metabolic processes and so helped to create an atmosphere containing a greater amount of oxygen. Other oxygen-requiring bacteria could then develop, along with additional lifeforms. There are other interesting bacteria that evolved abilities. to ferment glucose into lactic or acetic acid; perhaps we will explore these in a future article.
In contrast to bacteria, scientists debate if viruses are even alive since they are not capable of their own reproduction. Instead, they require the presence of a host in which they can introduce their genetic material. Through the formation of products encoded by the viral genetic material and by the use of aspects of the host's replication machinery, viruses are able to direct the manufacture and assembly of components to produce new viruses.
Scientists are in general agreement that the first virus was a fragment of DNA or ribonucleic acid (RNA) from an eventual prokaryotic or eukaryotic host. The genetic fragment was somehow incorporated into a eukaryote and became replicated along with the host's genetic material. Different viruses developed over time, each designed to take advantage of the evolving bacteria and eukaryotic cells. In other words, as bacteria increased in diversity and complexity, new viruses evolved to be able to utilize the bacteria as a replication factory. Similarly, as more complex eukaryotic lifeforms appeared- plants, insects, birds, and mammals- viruses evolved that were capable of utilizing them as well.
Fungi are organisms that are neither plants nor animals, but which exhibit some traits of both. Fungi cannot produce their own food (they do not have chlorophyll), so they rely on absorbing nutrients, usually from dead plants and animals. Yeast are a species of single-celled fungi that achieved notoriety for their ability to ferment sugars.
As you have seen, competition among plant species led to adaptation and resulted in different strategies for survival. Some grew taller, others adopted waxy coatings, and many, including white oaks, developed bitter-tasting tannins to defend against insect herbivores by deterrence and/or toxicity. The production of tannins as a strategy for survival has been so successful, that tannins are the most abundant secondary metabolites made by plants. And good for spirits enthusiasts too, since these tannins are responsible for much of the flavor that aged spirits get from their time in the barrel (but more on that later).
Yeast also evolved to keep microbes and bacteria from consuming all the nutrients around them. As yeast's tolerance for ethanol evolved alongside its ability to produce it, scientists believe that fermentation became yeast's survival strategy, inoculating their surroundings by killing competing bacteria and fungi.
Unsurprisingly, nature continues to evolve. Some changes go unnoticed while others have almost immediate consequences; perhaps, the most graphic of these evolutions happens in the world of bacteria and viruses, where some bacteria develop resistance to antibiotics (by producing enzymes that neutralize the antibiotics) and where strains of the flu virus mutate into new forms, sometimes from one year to the next.
So much has already been published about the history of fermentation and distillation that I won't bother repeating it. Suffice to say that humans love fermented and distilled beverages, but something interesting happened as early craftsmen looked for ways to store and transport those beverages in oak barrels: the tannins from the wood were extracted into the alcohol and, after sufficient resting time, the they became softer and mellower. The same tannins that plants evolved as deterrents against predators turned out to be appealing to our palates, but only after being oxidized (or reduced, if you are a chemist) during the barrel aging process.

Humans are the only animals known to willingly consume foods or substances that cause them irritation, discomfort, and even pain. Proposed theories explaining this range from thrill-seeking behaviors to an evolutionary adaptation for seeking foods that reduce pathogens. One of these explanations is known as "The Drunken Monkey Theory," which suggests that our attraction to alcohol evolved from a powerful sensory bias associating it with nutritional reward. Our ancestral primates evolved as fruit eaters in tropical rainforests, environments where yeast abounds and where fermentation is fast because of the warm and moist climate. While the ripe fruit may be hard to find visually, the smell of fermenting fruit can lead us more efficiently to it. Alcohol also stimulates feeding, just as it does in modern humans via the aperitif effect.
Humanity today relies on yeast to produce industrial and food-grade ethanol at an unprecedented scale. This dependence has ensured our protection and perpetuation of the yeast species needed for fermentation. Our reliance on white oak trees for barrels (again, for those delicious tannins) has also led to reforesting activities aimed at preserving these special trees long into the future. As evolutionary survival strategies go, fending off microbes and insects while stimulating humans into becoming their benefactors and protectors is definitely a winning combination!
Interested in advancing your knowledge of distilling and the spirits industry? Check out Moonshine University's upcoming courses to learn from the best in the business.
Written by Luis Ayala, Founder of Rum Central, Got Rum? magazine & The Rum University; Originally published by Artisan Spirit magazine - Fall 2019 (PDF). Luis is also a faculty member at Moonshine University, where he teaches at the 5-Day Rum Course.
Related Content
How to Pick the Best Yeast Strain for Your Distillery

blog
For decades, spirits and cocktails have fostered a culture of craft, connection, and celebration. But over time, cocktail culture has evolved far beyond the buzz!

blog
Those that are familiar with the process of crafting distilled spirits may also be familiar with the 10 common congeners that are created during fermentation, and honed during the distillation run. Each congener has its own distinct personality, rendering unique tastes and aromas to the finished spirit.

blog
So, you want to start distilling with freshly milled grain. Maybe you're tired of paying top dollar for the pre-milled stuff from the malt distributor, and you're ready to invest in the quality, efficiency, and bulk pricing that comes with milling your own whole grain. But where do you start?